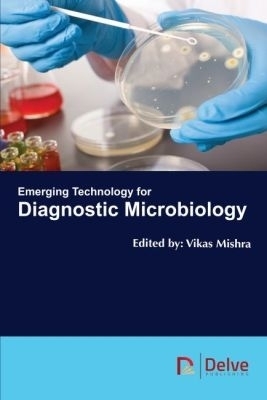
Emerging Technology for Diagnostic Microbiology -

Emerging Technology for Diagnostic Microbiology
Seiten
2018
Delve Publishing (Verlag)
978-1-77361-525-7 (ISBN)
Delve Publishing (Verlag)
978-1-77361-525-7 (ISBN)
- Titel z.Zt. nicht lieferbar
- Versandkostenfrei
- Auch auf Rechnung
- Artikel merken
Examines various aspects of microbiology, from fundamentals to emerging technologies. The book includes definitions of PCR in diagnostic virology, technology in molecular detection and strain typing of microbes and microarray for diagnostic microbiology.
Emerging Technology for Diagnostic Microbiology examines various aspects of microbiology from fundamentals to advanced emerging technology. It includes definitions of PCR in diagnostic virology, technology in molecular detection and strain typing of microbes and microarray for diagnostic microbiology. Provides the reader with insights into the development of emerging technologies of diagnostics microbiology, so as to understand its application, innovation.
Emerging Technology for Diagnostic Microbiology examines various aspects of microbiology from fundamentals to advanced emerging technology. It includes definitions of PCR in diagnostic virology, technology in molecular detection and strain typing of microbes and microarray for diagnostic microbiology. Provides the reader with insights into the development of emerging technologies of diagnostics microbiology, so as to understand its application, innovation.
Vikas Mishra obtained his Ph.D. from King George’s Medical University, India in 2010. His interests span from bio-resources, fermentation technology to medical virology and neuroscience research. He has been involved in the research regarding neurological manifestations in various conditions, notably, HIV, malaria, Alzheimer’s and traumatic brain injury.
| Erscheinungsdatum | 05.02.2019 |
|---|---|
| Sprache | englisch |
| Maße | 152 x 229 mm |
| Gewicht | 1025 g |
| Themenwelt | Medizin / Pharmazie ► Medizinische Fachgebiete ► Mikrobiologie / Infektologie / Reisemedizin |
| Studium ► 2. Studienabschnitt (Klinik) ► Anamnese / Körperliche Untersuchung | |
| Naturwissenschaften ► Biologie ► Mikrobiologie / Immunologie | |
| ISBN-10 | 1-77361-525-4 / 1773615254 |
| ISBN-13 | 978-1-77361-525-7 / 9781773615257 |
| Zustand | Neuware |
| Informationen gemäß Produktsicherheitsverordnung (GPSR) | |
| Haben Sie eine Frage zum Produkt? |
Mehr entdecken
aus dem Bereich
aus dem Bereich
Buch | Softcover (2024)
Urban & Fischer in Elsevier (Verlag)
CHF 78,40
aus Klinik und Praxis
Buch | Softcover (2023)
Urban & Fischer (Verlag)
CHF 58,75
Neurographie, Myographie, Evozierte Potenziale und EEG
Buch | Softcover (2024)
Urban & Fischer in Elsevier (Verlag)
CHF 79,95


